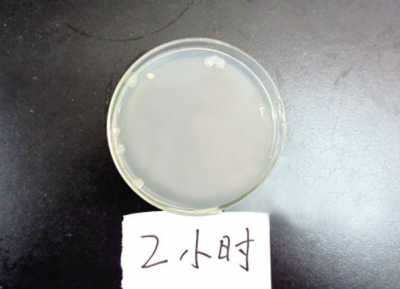
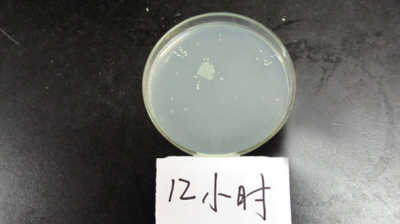
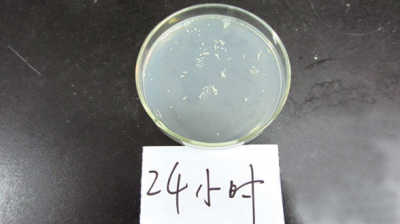
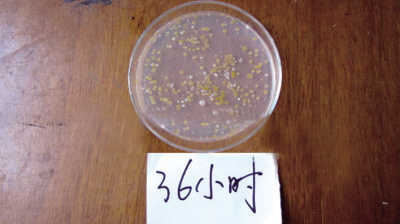

西瓜冷藏半天,细菌就猛涨(营养实验室) 等
 |
西瓜冷藏半天,细菌就猛涨(营养实验室)
专家提醒,吃前不妨将表面1厘米切掉

不同放置时间后,西瓜表面细菌生长情况。
炎炎夏日,西瓜又成了人们消暑的“抢手货”。切开后的西瓜吃不完,很多人习惯冷藏保存。但它到底能在冰箱里放多久呢?对此,江西科技师范大学生命科学学院微生物实验室的相关人员进行了一项实验,测定了西瓜冷藏不同时间后其表面细菌的数量,为大家揭示西瓜在冰箱里究竟能放多长时间。
, 百拇医药
实验人员先将西瓜、刀具等冲洗干净,把西瓜分别对半切开,依次编号1,2,3,4。将其在空气中放5分钟后,分别贴上保鲜膜,再放入冰箱。在2个小时、12个小时、24个小时和36个小时后,依次将西瓜取出,分别放入无菌台内刮取其表面5毫升左右作为样品,测定其细菌数量。
结果如图所示,通过菌落数的多少,能很直观地看到西瓜表面细菌数量的变化。由于细菌大小分布不均,实验人员对细菌数量进行了粗略计算。在冰箱存放2小时的西瓜,约有10多个菌落,冷藏12小时的有100多个,冷藏24小时的则有至少300个,冷藏36小时的至少达600个。
由此可见,就算西瓜放入冰箱,其表面依旧会滋生细菌。江西科技师范大学生命科学学院刘老师解释说,这是因为,在西瓜切开的过程中会沾染上细菌,冷藏只能抑制细菌的繁殖,并不能冻死病菌。再加上西瓜富含葡萄糖、果糖等多种营养物质,会为细菌的生长繁殖提供必备的原料。而这些致病菌往往会导致人食物中毒,引起腹泻等。此外,保鲜膜并不是万能的,有时也会有空气漏进去,并带入细菌。刘老师提醒,西瓜放入冰箱最好别超过12小时,最长不要超过24小时。此外,还要注意的是,在切西瓜时一定要事先把西瓜、刀具和案板清洗干净,西瓜最好现切现吃,吃不完的尽早盖上保鲜膜冷藏。江西省南昌市西湖区疾控中心胡玉城提醒,把冰箱里的西瓜拿出来吃时,可以先将表面约1厘米的部分切除。▲ (赵婉露)
, 百拇医药
每天两杯酸奶缓解焦虑(饮食新知)
美国科学家研究发现
酸奶富含有益菌,常喝对消化道有好处。据英国《每日电讯报》5月30日报道,美国一项新研究发现,每天喝两杯酸奶还可以缓解焦虑和压力。
美国加州大学医学院的研究人员选取了36名18~53岁的健康女性为研究对象。在为期一个月的研究中,参试者被随机分为三组:A组每天喝两杯含益生菌酸奶;B组喝不含益生菌的奶制品;C组不吃任何奶制品。所有参试女性分别在研究开始和结束时接受大脑核磁共振成像扫描检查。结果发现,喝益生菌酸奶的参试女性大脑中负责处理认知和情感的区域活动减少,其他两组女性大脑该区域的活动没有变化或者活动明显更活跃。迈尔博士分析指出,这一结果表明,肠道健康与大脑健康相互影响。酸奶在改变人体肠道菌群的同时,有助于改善情绪。▲
, 百拇医药
(徐澄)
快餐店冰块比马桶水还脏
英国一项最新调查显示
喝饮料时加些冰块,无疑是在酷暑天里最惬意的享受。然而,近日,英国《每日邮报》的一项最新监测结果显示,在60%的快餐店里,冰块中的细菌含量超过马桶水。
科研人员对麦当劳、汉堡王、肯德基、星巴克、CafeRouge咖啡连锁店和Nando烤鸡快餐店等10个英国快餐连锁店的冰块和马桶水进行了取样检测。结果发现,有6家餐厅的食用冰块所含细菌数量甚至超过马桶水,其中4家的细菌数量超过卫生标准。排名最高的Nando烤鸡快餐店冰块和马桶水细菌含量分别为2100个/毫升和1300个/毫升。肯德基的两项指标分别为1400个/毫升和260个/毫升。
, 百拇医药
英国健康保护局专家梅乐迪・格林伍德博士表示,很多人认为低温的冰块不会带菌,事实上,这是一大误解。冰块污染很多是因为外界因素所致,如制冰设备不洁净、工作人员不洗手、制冰设备不经常清洗等。就此,《生命时报》记者采访了北京市海淀区卫生局卫生监督所原队长谭梁之,他说,国内目前还没有相关的检测数据,但冰块中细菌确实可能会超标,而消费者单从外观很难确定冰块是否被污染,只能在喝饮料时尽量少加冰块。▲ (徐艺姗)
, http://www.100md.com